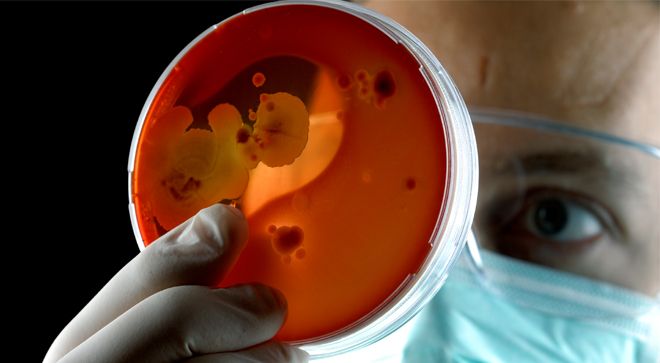

CE lesson worth 1 contact hour that is intended to advanced practice nurses, registered nurses, and other healthcare professionals who care for patients with cancer.


CE lesson worth 1 contact hour that is intended to advanced practice nurses, registered nurses, and other healthcare professionals who care for patients with cancer.

Selinexor (KPT-330), a promising drug that retards cell malignancy by blocking the transport of tumor-suppressor proteins out of the cell nucleus, is under investigation as combination therapy in heavily pretreated patients with relapsed/refractory multiple myeloma.

The MMRF was honored for the 15th year for outstanding stewardship of donors’ funds.

Researchers at the National Institutes of Health are exploring whether CAR T-cell therapy can enhance the effectiveness of treatment with hematopoietic cell transplant (HCT) among patients with relapsed/refractory acute lymphoblastic leukemia (ALL).

Patients with relapsed/refractory heavily pretreated multiple myeloma could live for an extra progression-free year with the use of the anti-BCMA CAR T-cell therapy bb2121.

The FDA has granted an accelerated approval to pembrolizumab (Keytruda) for the treatment of adult and pediatric patients with refractory primary mediastinal large B-cell lymphoma (PMBCL), or those who have relapsed after 2 or more prior lines of therapy.

Phyllis McKiernan, MSN, APN, OCN, Blood & Marrow Transplant Program, John Theurer Cancer Center explains factors that go into choosing an iron chelation therapy for a patient with myelodisplastic syndrome (MDS) experiencing transfusion-related iron overload.

Based on results from the phase III MURANO trial, the FDA has granted a regular approval to venetoclax (Venclexta) in combination with rituximab for the treatment of patients with chronic lymphocytic leukemia (CLL) or small lymphocytic lymphoma (SLL), with or without 17p deletion, following at least 1 prior therapy.

A promising CD19-directed chimeric antigen (CAR) T-cell therapy, Lisocabtagene maraleucel (JCAR017; liso-cel), may result in durable remissions among patients with high-risk diffuse large B-cell lymphoma (DLBCL), the most common type of non-Hodgkin lymphoma.

Patients with relapsed/refractory heavily pretreated multiple myeloma could live for an extra progression-free year with the use of the anti-BCMA CAR T-cell therapy bb2121.

The FDA approved sargramostim (Leukine) for the treatment of adult and pediatric with hematopoietic subsyndrome of acute radiation syndrome (H-ARS).

Immuno-Oncology (IO) and novel agents targeting the microenvironment were the focus of the 2018 annual meeting of the American Society of Clinical Oncology (ASCO).

The FDA has granted breakthrough therapy designation to the kinase inhibitor crizotinib (Xalkori) for two indications.

Oncology nurses play an important role in educating patients with chronic lymphocytic leukemia (CLL) about the adverse effects (AEs) associated with ibrutinib (Imbruvica) treatment.

When given before a stem cell transplant, busulfan plus melphalan, improved progression-free survival in patients with myeloma, but came with some extra adverse events.

A multidisciplinary team approach may help in seeing optimal patient outcomes following the administration of a powerful drug combination for patients with relapsed/refractory chronic lymphocytic leukemia (CLL).

Patient-reported outcomes allowed oncology nurses to better support patients’ needs.

The FDA has approved the monoclonal antibody daratumumab (Darzalex), in combination with bortezomib (Velcade), melphalan, and prednisone (VMP) for the treatment of patients with newly diagnosed multiple myeloma who are ineligible for autologous stem cell transplant.

The FDA has approved the chimeric antigen receptor (CAR) T-cell therapy tisagenlecleucel (Kymriah) for use in adult patients with relapsed/refractory large B-cell lymphoma—including diffuse large B-cell lymphoma (DLBCL), high grade B-cell lymphoma, and DLBCL arising from follicular lymphoma—after 2 or more lines of systemic therapy.

BLU-667 appeared to be well-tolerated and had broad clinical benefit among patients with advanced, RET-altered solid tumors who progressed on prior therapies, according to study findings from a phase I clinical trial presented at the AACR Annual Meeting 2018.

The FDA approved fostamatinib disodium hexahydrate (Tavalisse), an SYK inhibitor, as a second-line treatment for patients with chronic immune thrombocytopenia following insufficient response to a previous therapy.

Findings from a phase III randomized clinical trial offer new hope to some patients who have advanced myelofibrosis.

The FDA has granted a priority review to duvelisib for a full approval for the treatment of patients with relapsed/refractory chronic lymphocytic leukemia/small lymphocytic lymphoma (CLL/SLL) and an accelerated approval for the treatment of patients with relapsed/refractory follicular lymphoma.

The FDA has granted a priority review to moxetumomab pasudotox for the treatment of adult patients with hairy cell leukemia (HCL) who have received at least 2 prior lines of therapy, according to AstraZeneca (MedImmune), the developer of the anti-CD22 recombinant immunotoxin.
New research indicates that both a dependence on glycolysis and prior chemotherapy appear to reduce the potential for T cells to develop into chimeric antigen receptor (CAR) T-cell therapy.